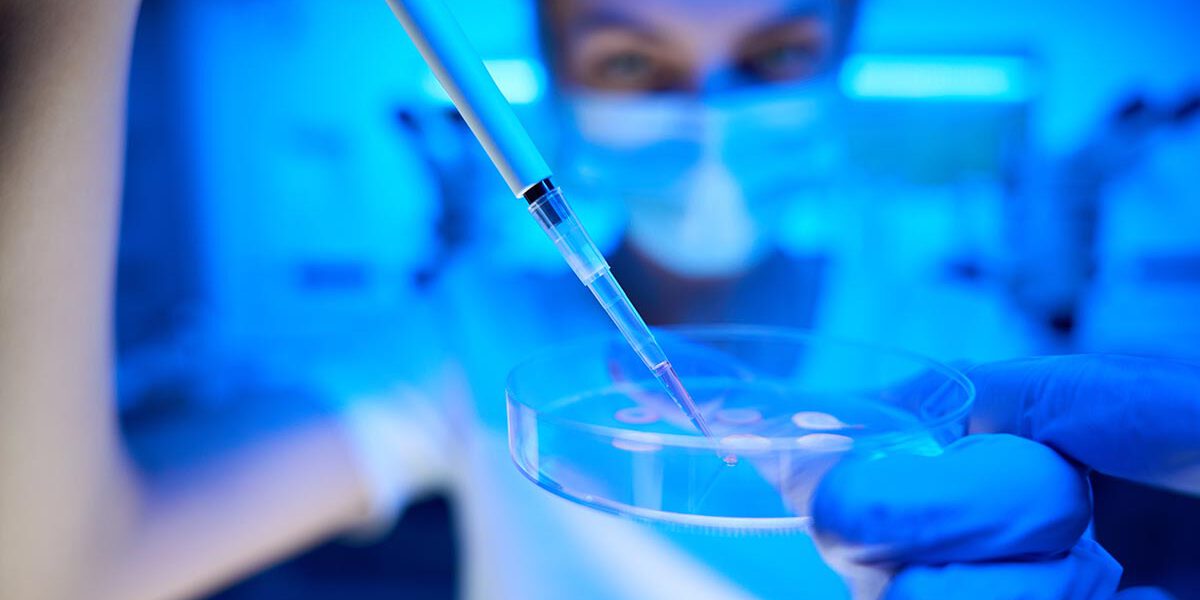

Deciding to embark on an IVF journey is a profound and emotional step towards making your dreams of parenthood a reality. At Infinite Surrogacy, we understand the hopes, concerns, and decisions involved in choosing the right path forward. Each IVF method offers unique possibilities, and we are here to guide you through these options with care and understanding.
Traditional IVF:
In traditional IVF, eggs and sperm are combined in a laboratory dish to allow fertilization to occur naturally. Though less commonly used today, it remains a viable option when there are no significant male fertility issues and when natural fertilization is preferred. This method can offer a sense of allowing nature to take its course within a supported environment.
IVF with ICSI (Intracytoplasmic Sperm Injection):
IVF with ICSI involves the precise injection of a single sperm directly into an egg. This advanced technique is ideal when male fertility challenges exist, such as low sperm count or poor motility, or when previous IVF attempts have not resulted in fertilization. ICSI provides hope and possibility, ensuring the fertilization process is as direct as possible.
Mini IVF Cycles:
Mini IVF aims to use lower doses of fertility medication for ovarian stimulation, focusing on retrieving fewer but higher-quality eggs. This approach is beneficial for women seeking to minimize the effects of medications or for those with a limited ovarian reserve. Mini IVF offers a gentler, more personalized approach, valuing quality over quantity.
At Infinite Surrogacy, we are committed to guiding you through this life-changing journey, ensuring each decision aligns with your aspirations and well-being.